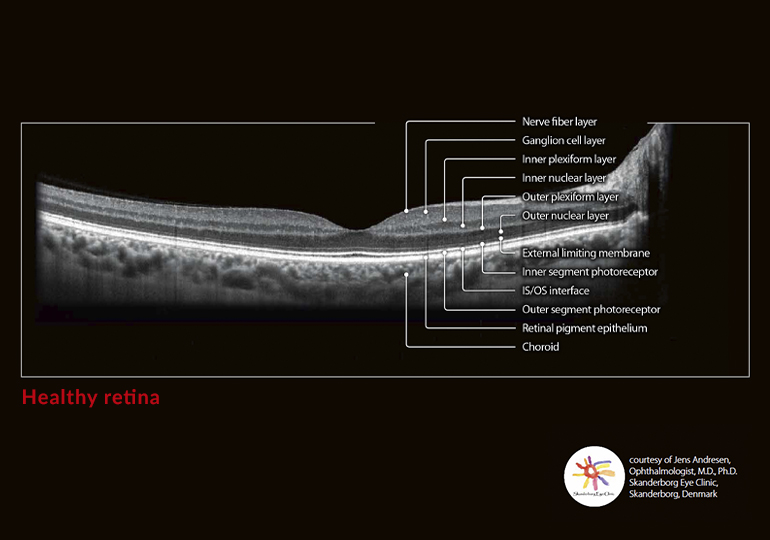
Going beyond the surface
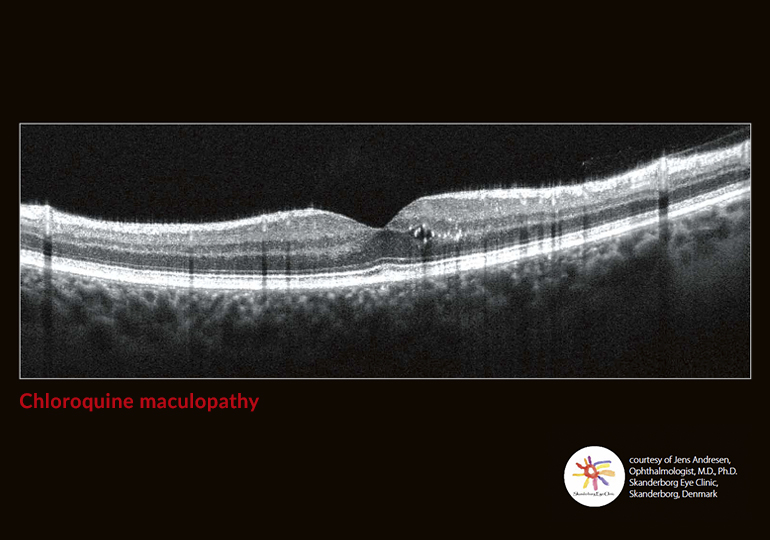
Going beyond the surface
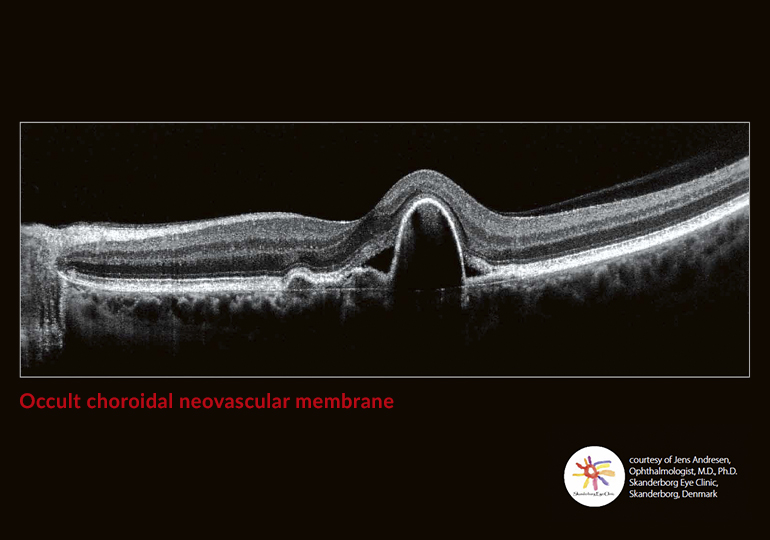
Going beyond the surface
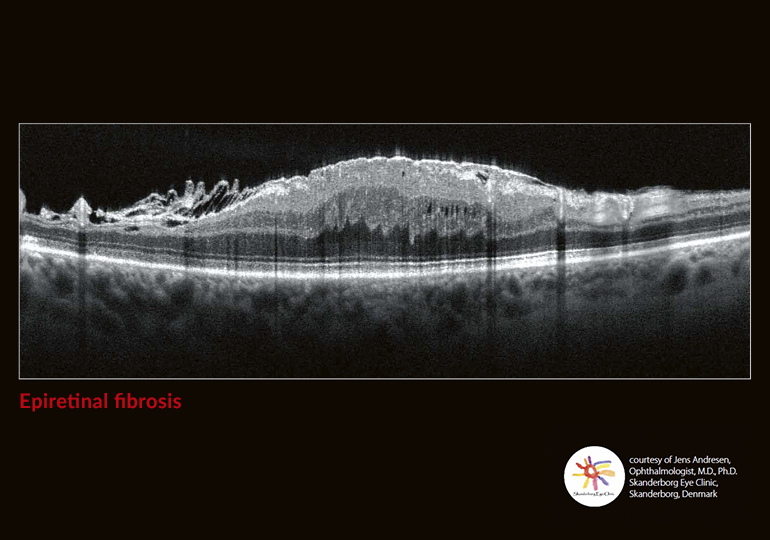
Going beyond the surface
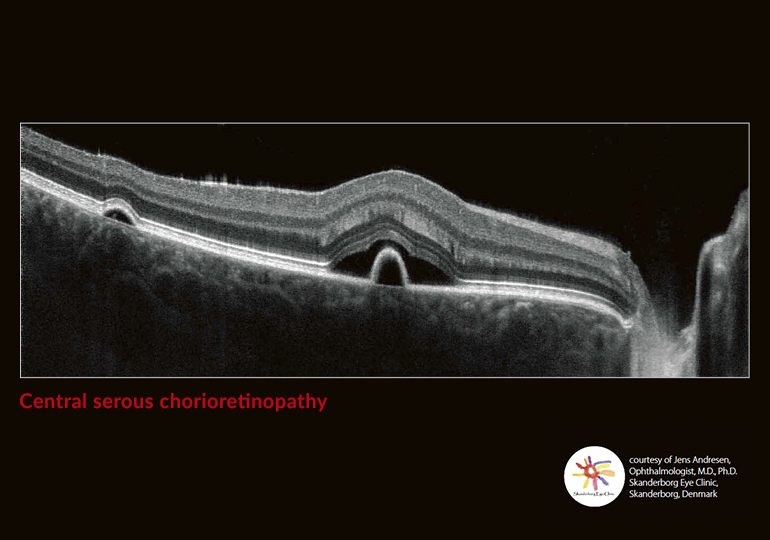
Going beyond the surface

Xephilio OCT-A1
Xephilio OCT-A1
Xephilio OCT-A1
Canon’s Xephilio OCT-A1 provides outstanding performance and exceptional ease of use. Superior image quality and a host of automated features optimize and simplify clinical examinations, while the system’s fast scanning speed enables short examination times, improving procedure efficiency and patients’ comfort.
Promotion
Key Features
Features

Fast and Easy Acquisition with Incredible Detail
With a digital resolution of up to 1.6μm, the system enables excellent differentiation of structures and individual layers of the retina. High scanning speed of 70,000 A-scans/s enables very short examination times of usually about two seconds, resulting in less motion artefacts and increased patient comfort.

Flow Fusion Technology and Deep Learning Technology Intelligent Denoise
Flow Fusion and the new AI-based Intelligent Denoise option can further improve the clinical outcomes of OCTA studies. These tools greatly enhance workflow and diagnostic confidence, providing excellent patient comfort and well-being.

Angio Expert HD Software
Angio Expert HD not only offers a wide range of advanced image quality tools, but also adds advanced OCTA analysis to the imaging portfolio. Angio Expert HD provides high pixel density and extended field of view, enabling the imaging of vessels and capillaries over a large area with high precision.
Specifications
Specifications
|
Scan Rate |
70,000 A-scan/second |
|
Axial Resolution (Digital/Optical) |
1.6/3μm |
|
Transversal Resolution |
20μm |
|
Wavelength |
SLD: 855nm, SLO: 780nm*1 |
|
Minimum Pupil Diameter |
3.0mm |
|
Working Distance |
35mm |
|
Fundus Imaging Method |
Flying spot SLO |
|
SLO Size (H x V) |
13mm x 10mm |
|
OCT Width |
3~13mm |
|
OCT Depth |
2.0mm |
|
Internal Fixation Light |
1 x 1mm or 6 x 6mm |
|
External Fixation Light |
EL-1 (option) |
|
Dimension and Weight |
|
|
Dimension (W x D x H) |
387 x 499 x 474mm |
|
Weight |
29kg |
|
OCT Scan Parameters |
|
|
Retina Scan Mode |
Vitreous and choroidal modes available C-gate direction: normal/inverse |
|
Macula 3D |
1024 A-scan x 128 (10 x 10mm) Horizontal |
|
Glaucoma 3D |
1024 A-scan x 128 (10 x 10mm) Vertical |
|
Disc 3D |
512 A-scan x 256 (6 x 6mm) Horizontal |
|
Custom 3D |
1024 A-scan x 128 Vertical/Horizontal |
|
Multi Cross |
1024 A-scan (horizontal 3 – 13mm, vertical 3 – 10mm) |
|
Cross |
1024 A-scan (horizontal 3 – 13mm, vertical 3 – 10mm) |
|
Radial |
1024 A-scan (3mm/6mm/10mm) |
|
OCTA |
OCT angiography |
|
Anterior Scan Mode (Option) |
C-gate direction: Normal |
|
Anterior 3D |
6mm Horizontal |
|
Anterior Cross |
3mm/6mm Horizontal |
|
Anterior Radial |
6mm 12 directions (15 degrees interval) |
- Output on cornea < 1.5mW for SLD, 1.0mW for SLO (scanning beam controlled by the laser safety system)
Product Disclaimer
- 01. Prices, specifications, availability and terms of offers may change without notice.
- 02. Products / Services may be manufactured by and/or supplied to us by third party manufacturers/suppliers for distribution / resale (non-Canon brand products).
- 03. Prices above are recommended retail price in Malaysian Ringgit and may change without prior notice.